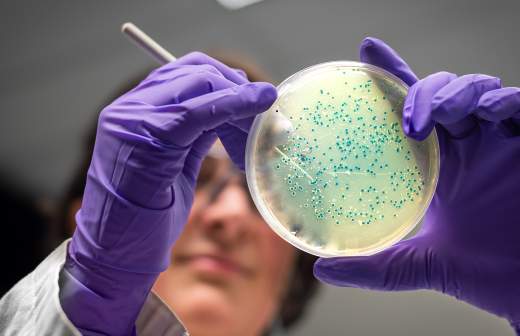

Врач от бота: антибиотики перед операцией подберут через Telegram

В России создали чат-бот, способный подобрать пациенту необходимые перед операцией антибиотики. Он предназначен для хирургов и клинических фармакологов и поможет принять обоснованное решение о необходимости приема противомикробных средств. Разработка позволит не только снизить рутинную нагрузку на врача, но и поспособствует в борьбе с устойчивыми спупербактериями, из-за которых самые простые и распространенные инфекции могут оказаться смертельными, считают эксперты.
Оценит риски
Команда молодых ученых Цифровой кафедры Сеченовского университета Минздрава РФ разработала Telegram-бота для хирургов и клинических фармакологов, который поможет принять обоснованное решение о необходимости приема антибиотиков пациентам перед операцией. С помощью бота специалист также сможет подобрать оптимальный препарат с учетом состояния больного, его веса, вида планируемого вмешательства и его продолжительности, риска развития инфекционных осложнений и аллергических реакций.
Разработанный чат-бот способствует рациональному подходу к использованию антибиотиков при оперативных вмешательствах, рассказал автор проекта, врач-терапевт Олег Бухтин. В бот также заложена функция обновления алгоритма тактики при появлении новых клинических рекомендаций.
— Профилактическое применение антибиотиков перед операцией проводится для снижения частоты развития послеоперационных раневых инфекций, — объяснил разработчик. — Сейчас хирурги и клинические фармакологи принимают решение о назначении антибиотиков на основании подсчета баллов по трем специальным шкалам. Их нужно постоянно иметь под рукой или просто запомнить. У начинающих специалистов подсчеты баллов и определение тактики лечения могут занимать достаточно много времени. Наш бот позволит значительно его сократить.
Чат-бот формирует рекомендации на основе протокола периоперационной профилактики. При его использовании врачу необходимо ответить на несколько вопросов — принимает ли пациент сейчас антибиотики, есть ли у него тяжелые сопутствующие патологии, сколько предположительно будет длиться операция и в какой области, были ли у пациента ранее аллергические реакции на прием актибактериальных препаратов и другие. С помощью алгоритма бот при обработке ответов автоматически подсчитывает баллы и на их основе выдает решение о необходимости приема противомикробных средств.
Против супербактерий
— Наш чат-бот не только поможет хирургам и клиническим фармакологам определять тактику лечения пациентов, готовящихся к операции, но и избежать необоснованного назначения антибиотиков и развития антибиотикорезистентности — толерантности микроорганизмов к препаратам, применяемым для лечения инфекций. На глобальном уровне это ускоряет появление и распространение супербактерий, которые препятствуют эффективному лечению инфекций, — рассказал Олег Бухтин.
Пока функционал чат-бота органичен только периоперационной профилактикой. В дальнейших планах разработчиков — провести тестирование цифрового помощника, получить отзывы врачей и усовершенствовать функционал бота для подбора антибиотиков при различных заболеваниях.
Антибиотикорезистентность — это проблема, актуальность которой повышается с каждым годом, и если не принимать мер, то в будущем нас может настигнуть эра, когда самые простые и распространенные инфекции могут оказаться смертельными, сказала ведущий консультант по лабораторной медицине, ведущий эксперт Центра молекулярной диагностики ФБУН ЦНИИ эпидемиологии Роспотребнадзора Маргарита Провоторова. Поэтому создание чат-бота — это важный шаг в оптимизации работы врачей и борьбе с растущей проблемой.
— Автоматизация рутинных процедур подбора антибиотиков с учетом индивидуальных факторов пациента может существенно облегчить работу медицинского персонала, освободив время для более сложных клинических задач. Внедрение подобных интеллектуальных систем поддержки принятия решений может стать важным шагом на пути к более персонализированному подходу лечения пациентов, — считает эксперт.
Подобные сервисы будут полезны, так как они позволят упростить рутинную работу, считает заведующий лабораторией анализа показателей здоровья населения и цифровизации здравоохранения МФТИ Станислав Отставнов.
— Очевидно, что объективная «машина», основанная на адекватных правилах, как минимум сможет расширить возможности субъективного специалиста, — считает он.
Однако необходимо дождаться результатов применения чат-бота в клинической практике, уверены специалисты.
Устойчивость к противомикробным препаратам возникает, когда микробы развивают механизмы, которые защищают их от воздействия таких лекарств. По данным ВОЗ, резистентность возрастает до угрожающе высоких уровней во всем мире. Всё больше инфекций, например пневмонию, туберкулез, заражение крови, гонорею, отравления, становится лечить труднее, а иногда это и вовсе невозможно из-за снижения эффективности антибиотиков.